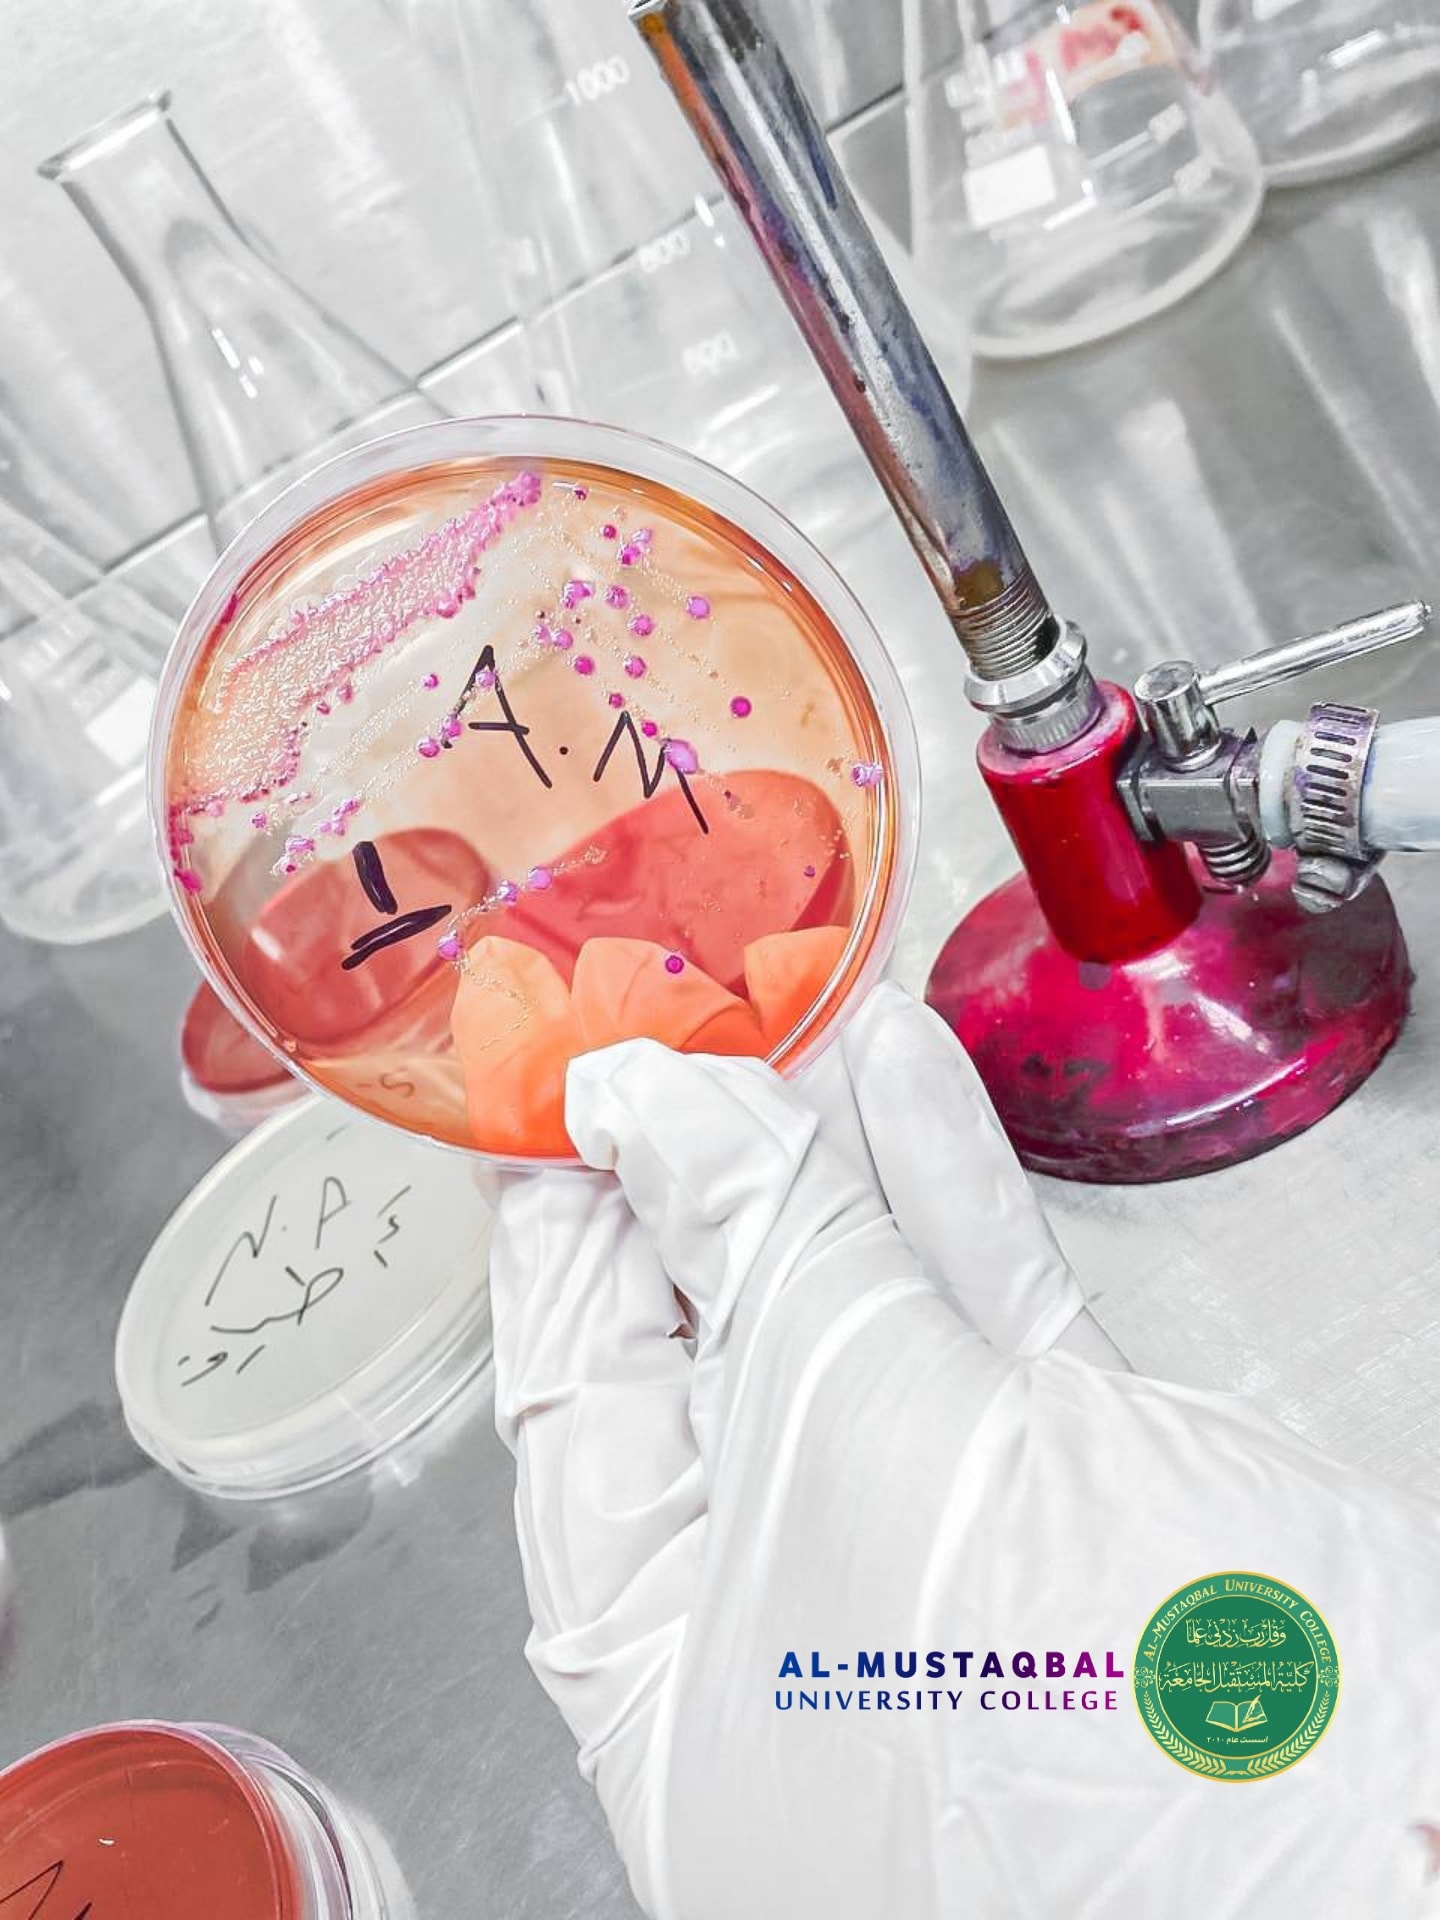
default image

طلبة قسم تقنيات المختبرات الطبية المرحلة الرابعة في كلية المستقبل الجامعة يواصلون العمل بمشاريع التخرج
421
طلبة قسم تقنيات المختبرات الطبية المرحلة الرابعة في كلية المستقبل الجامعة يواصلون العمل بمشاريع التخرج بعد تقسيمهم الى مجاميع حيث كان احدى مشاريع التخرج بعنوان<br />"عزل وتشخيص الأحياء المجهرية من الحليب ومشتقاته"Isolation and identification of pathogenic bacteria isolated from some milk products<br />جاء ذلك بإشراف د. زهراء عبد المهدي التي اكدت ان البيئة الدراسية التي توفرها كلية المستقبل تساعد وبشكل كبير الطلبة على انجاز مشاريع التخرج<br /><br />وحدة اعلام كلية المستقبل الجامعة